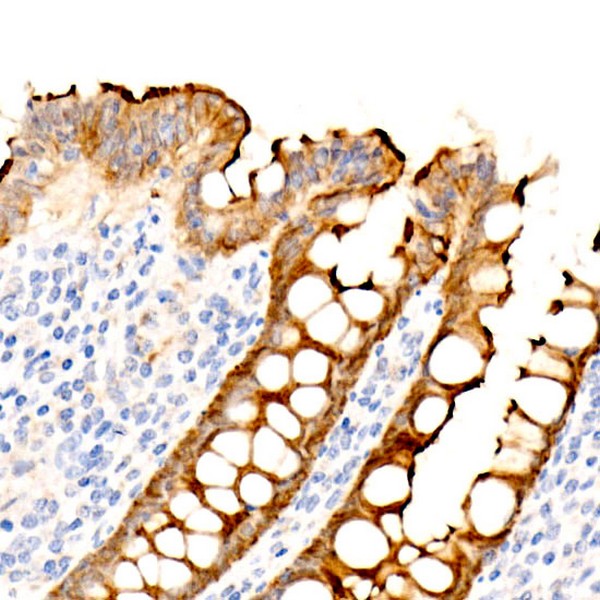
Villin Rabbit mAb (Catalog Number: A22051) Abclonal

Villin Rabbit mAb (A22051)
$148.00 – $548.00
Abclonal Villin Rabbit mAb (Catalog Number: A22051) encodes a member of a family of calcium-regulated actin-binding proteins. This protein represents a dominant part of the brush border cytoskeleton which functions in the capping, severing, and bundling of actin filaments.
- Details & Specifications
- References
| Catalog No. | A22051 |
|---|---|
| Product Name | Villin Rabbit mAb (A22051) |
| Supplier Name | ABclonal, Inc. |
| Brand Name | Abclonal |
| Synonyms | VIL; D2S1471 |
| Gene Name | VIL1 |
| Protein Name | VIL1 |
| Uniprot/Swissprot ID | P09327 |
| Gene ID | 7429 |
| Clone | ARC54727 |
| Clonality | Monoclonal |
| Source/Host | Rabbit |
| Reactivity | Human, Mouse, Rat |
| Conjugate | Unconjugated |
| Note | Products will be shipped from the warehouse in Massachusetts. Promotion is running from time to time. Welcome to send a request for quote to message@sydlabs.com. |
| Order Offline | Syd Labs, Inc. 4 Avenue E, Hopkinton, MA 01748 USA. Phone: 1-617-401-8149 Fax: 1-617-606-5019 Email: message@sydlabs.com |
Description
A22051: Villin Rabbit mAb
This gene encodes a member of a family of calcium-regulated actin-binding proteins. This protein represents a dominant part of the brush border cytoskeleton which functions in the capping, severing, and bundling of actin filaments. Two mRNAs of 2.7 kb and 3.5 kb have been observed; they result from utilization of alternate poly-adenylation signals present in the terminal exon.
Immunogen Information about Villin Rabbit mAb (A22051)
Immunogen:Recombinant fusion protein containing a sequence corresponding to amino acids 1-827 of human Villin1 (NP_009058.2).
Sequence:MTKLSAQVKGSLNITTPGLQIWRIEAMQMVPVPSSTFGSFFDGDCYIILAIHKTASSLSYDIHYWIGQDSSLDEQGAAAIYTTQMDDFLKGRAVQHREVQGNESEAFRGYFKQGLVIRKGGVASGMKHVETNSYDVQRLLHVKGKRNVVAGEVEMSWKSFNRGDVFLLDLGKLIIQWNGPESTRMERLRGMTLAKEIRDQERGGRTYVGVVDGENELASPKLMEVMNHVLGKRRELKAAVPDTVVEPALKAALKLYHVSDSEGNLVVREVATRPLTQDLLSHEDCYILDQGGLKIYVWKGKKANEQEKKGAMSHALNFIKAKQYPPSTQVEVQNDGAESAVFQQLFQKWTASNRTSGLGKTHTVGSVAKVEQVKFDATSMHVKPQVAAQQKMVDDGSGEVQVWRIENLELVPVDSKWLGHFYGGDCYLLLYTYLIGEKQHYLLYVWQGSQASQDEITASAYQAVILDQKYNGEPVQIRVPMGKEPPHLMSIFKGRMVVYQGGTSRTNNLETGPSTRLFQVQGTGANNTKAFEVPARANFLNSNDVFVLKTQSCCYLWCGKGCSGDEREMAKMVADTISRTEKQVVVEGQEPANFWMALGGKAPYANTKRLQEENLVITPRLFECSNKTGRFLATEIPDFNQDDLEEDDVFLLDVWDQVFFWIGKHANEEEKKAAATTAQEYLKTHPSGRDPETPIIVVKQGHEPPTFTGWFLAWDPFKWSNTKSYEDLKAELGNSRDWSQITAEVTSPKVDVFNANSNLSSGPLPIFPLEQLVNKPVEELPEGVDPSRKEEHLSIEDFTQAFGMTPAAFSALPRWKQQNLKKEKGLF
Gene ID:7429
Swiss prot:P09327
Synonyms:VIL; D2S1471; Villin
Calculated MW:93kDa
Observed MW:93kDa
Images of Villin Rabbit mAb (A22051)

Western blot analysis of extracts of various cell lines, using Villin1 antibody (A22051) at1:20000 dilution.
Secondary antibody: HRP Goat Anti-Rabbit IgG (H+L) (AS014) at 1:10000 dilution.
Lysates/proteins: 25μg per lane.
Blocking buffer: 3% nonfat dry milk in TBST.
Detection: ECL Basic Kit (RM00020).
Exposure time: 10s.

Western blot analysis of extracts of Rat pancreas, using Villin1 antibody (A22051) at1:20000 dilution.
Secondary antibody: HRP Goat Anti-Rabbit IgG (H+L) (AS014) at 1:10000 dilution.
Lysates/proteins: 25μg per lane.
Blocking buffer: 3% nonfat dry milk in TBST.
Detection: ECL Basic Kit (RM00020).
Exposure time: 180s.

Immunohistochemistry analysis of paraffin-embedded human appendix using Villin1 Rabbit mAb (A22051) at dilution of 1:300 (40x lens).Perform high pressure antigen retrieval with 10 mM Tris/EDTA buffer pH 9.0 before commencing with IHC staining protocol.

Immunohistochemistry analysis of paraffin-embedded human colon using Villin1 Rabbit mAb (A22051) at dilution of 1:300 (40x lens).Perform high pressure antigen retrieval with 10 mM Tris/EDTA buffer pH 9.0 before commencing with IHC staining protocol.
Please remember our product information: Villin Rabbit mAb (Catalog Number: A22051) Abclonal